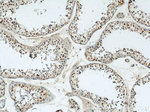
CUL4B Antibody in Immunohistochemistry (Paraffin) (IHC (P))

Search
Proteintech
CUL4B Polyclonal Antibody
{{$productOrderCtrl.translations['antibody.pdp.commerceCard.promotion.promotions']}}
{{$productOrderCtrl.translations['antibody.pdp.commerceCard.promotion.viewpromo']}}
{{$productOrderCtrl.translations['antibody.pdp.commerceCard.promotion.promocode']}}: {{promo.promoCode}} {{promo.promoTitle}} {{promo.promoDescription}}. {{$productOrderCtrl.translations['antibody.pdp.commerceCard.promotion.learnmore']}}
产品信息
12916-1-AP
种属反应
已发表种属
宿主/亚型
分类
类型
抗原
偶联物
形式
浓度
规格
纯化类型
保存液
内含物
保存条件
运输条件
产品详细信息
Immunogen sequence: MMSQSSGSG DGNDDEATTS KDGGFSSPSP SAAAAAQEVR SATDGNTSTT PPTSAKKRKL NSSSSSSSNS SNEREDFDST SSSSSTPPLQ PRDSASPSTS SFCLGVSVAA SSHVPIQKKL RFEDTLEFVG FDAKMAEESS SSSSSSSPTA ATSQQQQLKN KSILISSVAS VHHANGLAKS STTVSSFANS KPGSAKKLVI KNFKDKPKLP ENYTDETWQK LKEAVEAIQN STSIKYNLEE LYQAVENLCS YKISANLYKQ LRQICEDHIK AQIHQFREDS LDSVLFLKKI DRCWQNHCRQ MIMIRSIFLF LDRTYVLQNS MLPSIWDMGL ELFRAHIISD QKVQNKTIDG IL (1-351 aa encoded by BC036216)
靶标信息
Core component of multiple cullin-RING-based E3 ubiquitin-protein ligase complexes which mediate the ubiquitination and subsequent proteasomal degradation of target proteins. The functional specificity of the E3 ubiquitin-protein ligase complex depends on the variable substrate recognition subunit. CUL4B may act within the complex as a scaffold protein, contributing to catalysis through positioning of the substrate and the ubiquitin-conjugating enzyme. Plays a role as part of the E3 ubiquitin-protein ligase complex in polyubiquitination of CDT1, histone H2A, histone H3 and histone H4 in response to radiation-induced DNA damage. Targeted to UV damaged chromatin by DDB2 and may be important for DNA repair and DNA replication. Required for ubiquitination of cyclin E, and consequently, normal G1 cell cycle progression. Regulates the mammalian target-of-rapamycin (mTOR) pathway involved in control of cell growth, size and metabolism. Specific CUL4B regulation of the mTORC1-mediated pathway is dependent upon 26S proteasome function and requires interaction between CUL4B and MLST8.
仅用于科研。不用于诊断过程。未经明确授权不得转售。
生物信息学
蛋白别名: CUL-4B; cul4b; Cullin-4B; ubiquitin E3 ligase; unnamed protein product
基因别名: 2700050M05Rik; AA409770; CUL-4B; CUL4B; KIAA0695; mKIAA0695; MRXHF2; MRXS15; MRXSC; SFM2
UniProt ID: (Human) Q13620, (Mouse) A2A432
Entrez Gene ID: (Human) 8450, (Mouse) 72584